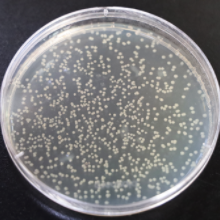

E.coli protein expression system
The Escherichia coli protein expression system is currently the most widely used and cost-effective protein expression system. E.coli has characteristics such as well-understood genetic background, rapid cell proliferation, high expression levels, good stability, and strong anti-contamination ability.It is suitable for the expression of proteins from various genera, and have special advantages in the production of small-sized proteins. However, it also has some problems, such as the tendency to form inclusion bodies and the presence of endotoxins.
Biortus provides one-stop services from gene to recombinant protein expression/purification to meet the customized requirements. We have extensive experience in E.coli protein expression/purification as well as protein refolding. With a variety of E.coli cell lines and expression vectors at our disposal, we can offer customers high-quality prokaryotic protein expression services.

Service Details
• A variety of commercial strains are available (such as BL21(DE3), BL21(DE3)pLysS, BL21(DE3)(CodonPlus)-RIPL, Rosetta(DE3)pLysS, Rosetta2(DE3), Origami2, Rosetta-gami2(DE3), etc.);
• Inducible expression at different temperatures (16°C-37°C);
• Different culture media can be tested (LB, TB, 2xYT, M9, etc.);
• Different induction methods can be chosen (IPTG induction, arabinose induction, auto-induction, etc.);
• Co-expression of chaperone can be chosen to improve protein solubility (pG-TF2, pGro7, pTf16, pG-KJE8);
• High-throughput expression test based on 96-well plates available (able to test expression conditions in different strains and different constructs);
• Expression of isotope-labeled proteins (including 15N labeling, 13C labeling, 15N13C double labeling, 13C-Met and other selective labelings);
• Large-scale expression in E.coli shake flasks and high-density fermentation, up to 4000 L per month.
Experimental Procedures
-

![]()
Transformation (2 days)
-

![]()
5 mL small-scale test (2 days)
-

![]()
Scale-up expression (1-2 days)
Instruments
-
Shaker

![]()
-
5L fermentor

![]()
-
40L fermentor

![]()

Protein expression
Protein expression

